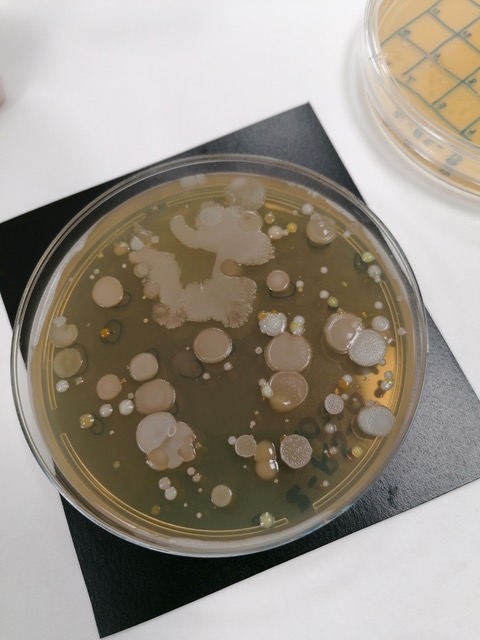
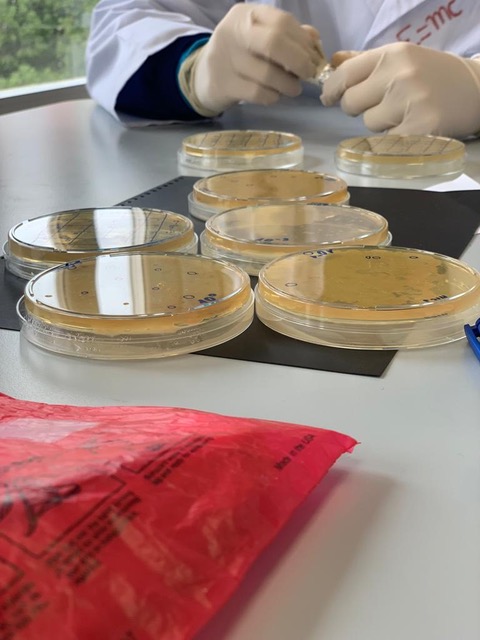

Los estudiantes investigan la biodiversidad microbiana de los suelos de su localidad en busca de bacterias que produzcan nuevos antibióticos.
Artículo originalmente publicado en el suplemento de ciencia y tecnología de Heraldo de Aragón Tercer Milenio, el 17/11/2022. Puede consultarse aquí.
La resistencia a los antibióticos (sustancias de origen natural o sintético utilizados para tratar infecciones bacterianas) es hoy una de las mayores amenazas para la salud mundial, la seguridad alimentaria y el desarrollo. Este problema se agrava por el escaso interés de la industria farmacéutica por desarrollar nuevos antibióticos. Encontrar nuevos antibióticos para luchar contra las bacterias resistentes es uno de los objetivos del proyecto MicroMundo. MicroMundo se basa en las iniciativas norteamericanas Small World Initiative (SWI) y Tiny Earth (TE). Es un proyecto global de ciencia ciudadana en el que miles de jóvenes estudiantes investigan la biodiversidad microbiana de los suelos de su localidad en busca de bacterias que produzcan nuevos antibióticos, un fenómeno común que utilizan muchas bacterias para competir entre ellas por el nicho ecológico.
Desde que en los años 40 el microbiólogo Selman Waksman analizó sistemáticamente microbios del suelo y descubrió la estreptomicina (primer
antibiótico utilizado para tratar la tuberculosis), las investigaciones sobre la producción de antibióticos a partir de bacterias presentes en el suelo continuaron hasta los años 60, y a partir de ellas se descubrieron las principales clases de antibióticos utilizados en la actualidad (tetraciclina, eritromicina,…). Inspiradas por estos fenómenos, las iniciativas SWI y TE se fueron extendiendo por varios países del mundo; llegaron a España en 2016 de la mano de la Universidad Complutense de Madrid, y en la actualidad han llegado a más de 30 universidades de nuestro país. En España, MicroMundo se lleva a cabo como un Proyecto de Aprendizaje- Servicio que involucra dos niveles educativos: universitario y preuniversitario. Un equipo formado por 3-5 estudiantes universitarios y supervisado por un investigador del campo de la microbiología, acude a un centro de enseñanza secundaria o bachillerato, donde se integra a los alumnos en este proyecto de investigación internacional.
Microorganismos presentes en las muestras de suelo. Imagen: MicroMundo
Placas que contienen los microorganismos presentes en las muestras de suelo. Imagen: MicroMundo
Los experimentos se desarrollan en el laboratorio del centro educativo durante varias sesiones, en las que se analizan las muestras de tierra recogidas por los propios alumnos de secundaria, se cultivan los microorganismos presentes y se investiga si son productores de antibióticos. Así, los estudiantes emulan el célebre experimento de Fleming que condujo al descubrimiento fortuito de la penicilina, aunque de una manera dirigida. Al mismo tiempo, se realiza una gran labor divulgativa acerca del grave problema actual de la resistencia a los antibióticos, transmitiendo el mensaje de la OMS para fomentar su uso racional, y se acerca a los estudiantes la figura del investigador, desmitificando a los científicos, y mostrando la importancia de la ciencia en cuestiones y problemas de la vida diaria.
Han participado 67 alumnos universitarios y 388 de secundaria y Bachillerato MicroMundo empezó en la Universidad de Zaragoza en el curso 2017-18, coordinado por la Dra. Ainhoa Lucía y el Dr. José Antonio Aínsa. Cada curso se incorporan a MicroMundo nuevos miembros de la comunidad universitaria con el objetivo de llegar a un mayor número de centros educativos. Hasta ahora han participado 67 alumnos universitarios (Biotecnología, Veterinaria y Ciencia y Tecnología de Alimentos) y 388 alumnos de secundaria y bachillerato pertenecientes a 17 centros educativos de Aragón. Los centros se han mostrado entusiasmados con la experiencia, que está resultando muy gratificante para los estudiantes que participan, y les ayuda a descubrir su vocación científica e investigadora.
Además, desde el punto de vista científico, los resultados están siendo muy interesantes: se han analizado más de 3000 microorganismos procedentes de casi 200 muestras de suelo diferentes, y hasta ahora se han obtenido más de 300 microorganismos productores de alguna sustancia antibiótica, que serán caracterizados en un futuro. Si te interesa saber cómo continúa este proyecto, puedes encontrar más información en sus redes sociales: Twitter (@MicroMundoUZ) Instagram
(@micromundoaragon) y Facebook (MicroMundoUnizar).
Ainhoa Lucía Quintana es investigadora Senior en la Universidad de Zaragoza, se ha dedicado a la investigación de nuevas terapias antimicrobianas, y es una amante de los proyectos educativos y divulgativos.
José Antonio Aínsa es profesor Titular de Microbiología en la Universidad de Zaragoza, su labor investigadora se ha centrado en la caracterización de antimicrobianos y en el estudio de los mecanismos de resistencia a antibióticos.